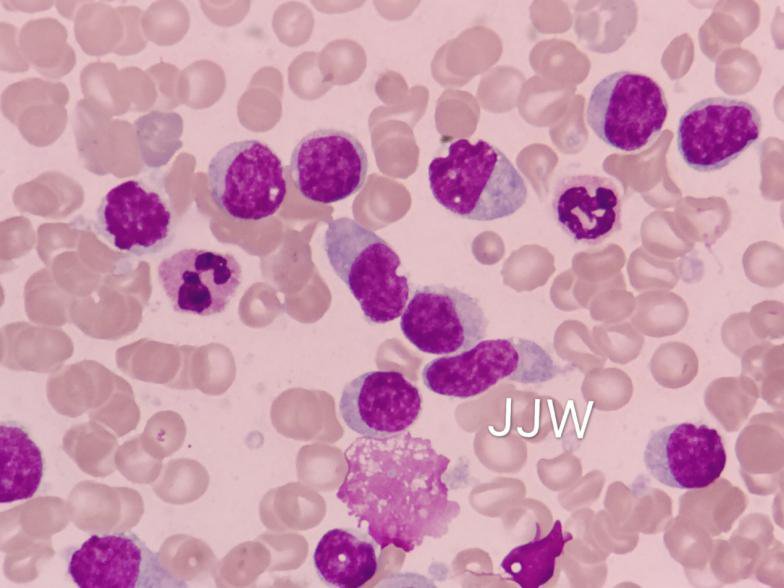

貝克曼庫爾特商貿(mào)(中國)有限公司
白金會員
已認(rèn)證

貝克曼庫爾特商貿(mào)(中國)有限公司
白金會員
已認(rèn)證
患者:性別女,年齡 80 歲。
主訴:乏力 10 余天,發(fā)現(xiàn)血象異常 2 天。
現(xiàn)病史:患者 10 余天前在家中無明顯誘因下出現(xiàn)乏力,伴胃納減退至平素 1/2,伴胸悶氣促,活動后明顯,休息數(shù)分鐘后自行緩解,伴口干明顯……起初未予重視未診治。后患者自覺癥狀無明顯緩解或加重,2 天前至我院門診查血常規(guī)。
血常規(guī):白細(xì)胞計數(shù):80.23x10^9/L;中性粒細(xì)胞百分?jǐn)?shù):0.16;血小板計數(shù):30x10^9/L;超敏 C-反應(yīng)蛋白 (全血):44.92 mg/L;異常淋巴細(xì)胞 56%,建議住院進(jìn)一步完善檢查明確診斷。
現(xiàn)患者乏力、胃納減退基本同前,無發(fā)熱畏寒,無胸悶氣促,無心慌心悸,無咳嗽咳痰等不適,查新型冠狀病毒核酸檢測陰性,為求進(jìn)一步診治,擬「急性白血病可能」收住入院。(點擊「閱讀原文」查看完整詳細(xì)病史、既往史、家族史信息)
既往有「高血壓病」病史 20 余年、有「冠心病」病史 7 年余、有「右側(cè)胸壁」腫物病史 2 月余,術(shù)后病理提示「粒細(xì)胞肉瘤」,現(xiàn)手術(shù)瘢痕處、胸壁廣泛多發(fā)暗紅色結(jié)節(jié),最大者約 2.5 cm,高出皮面,表面粗糙,質(zhì)韌,邊界清晰,表面無破潰流膿。雙側(cè)頸部、鎖骨上、腋窩、腹股溝未及腫大淋巴結(jié)。未治療。
右側(cè)胸壁病理診斷
鏡下描述:腫瘤由小圓細(xì)胞構(gòu)成,呈片狀彌漫性排列,浸潤性生長,累犯至真皮下纖維脂肪組織及橫紋肌組織。
病理診斷:「右胸壁」小圓細(xì)胞惡性腫瘤,淋巴造血系統(tǒng)腫瘤首先考慮,結(jié)合免疫組化考慮粒細(xì)胞肉瘤;該病例經(jīng)上級醫(yī)院病理專家討論。
鏡下所見:

診治經(jīng)過:患者入院后完善相關(guān)輔助檢查,彩超心臟:主動脈硬化。EF:79%。彩超肝、膽、胰、脾:肝門部多發(fā)低回聲,淋巴結(jié)考慮。脾腫大,脾內(nèi)多發(fā)高回聲,建議增強(qiáng) CT 等進(jìn)一步檢查。膽囊多發(fā)結(jié)石。膽囊內(nèi)膽泥淤積。床邊心電圖:1. 竇性心律 2. T 波改變。MRCP(膽道系統(tǒng)成像):脾臟多發(fā)惡性腫瘤,脾腫大,肝門部、腹膜后多發(fā)腫大淋巴結(jié)。膽囊多發(fā)結(jié)石。后腹膜 CT;肝膽脾 CT;盆腔 CT:脾臟多發(fā)惡性腫瘤,肝門區(qū)、后腹膜多發(fā)腫大淋巴結(jié),胸腹壁多發(fā)結(jié)節(jié),請結(jié)合臨床。膽囊結(jié)石。盆腔少量積液。附見:左側(cè)少量胸腔積液。
02.21 骨髓涂片:形態(tài)圖(東陽市人民醫(yī)院檢驗科蔣錦文老師供圖)

骨髓檢查報告:涂片有核細(xì)胞增生極度活躍,異常淋巴細(xì)胞明顯增高約 72.0%,淋巴瘤細(xì)胞白血病首先考慮。
2.20 骨髓細(xì)胞免疫分型檢查
通過流式細(xì)胞法進(jìn)行流式骨髓細(xì)胞免疫分型檢查,所用儀器為貝克曼庫爾特公司的 Navios 三激光十色流式細(xì)胞分析儀,流式結(jié)果通過 Kaluza 流式數(shù)據(jù)分析軟件進(jìn)行分析。
檢測結(jié)果:異常細(xì)胞(紅色)FS 小至中等,SS 偏大,占比 84.94%;
- 表達(dá):CD56、HLA-DR、CD4、CD123、CD43、CD303;
- 弱表達(dá):CD7、CD45RA、CD304、CD11c、CD117 、CD33、CD38、CD36;
- 不表達(dá):CD34、CD13、cyMPO、TDT、cyCD3、cyCD79a、CD3、CD30、CD22、CD20、CD15、CD10、CD57、Kappa、Lambda、CD45RO、CD8、CD5、CD16、CD14、CD64、CD11b、CD26、CD2、CD117;
患者皮膚腫塊病理險誤診,真相是?后續(xù)治療如何?
掃描下方二維碼或點擊「閱讀原文」,按引導(dǎo)提交信息后點擊「病例分享匯」-「腫瘤科」即可查看完整診斷結(jié)果及病例分析思考,參與互動還有機(jī)會獲得精美禮品。

個人簡介:張龍一,主管檢驗技師,執(zhí)業(yè)醫(yī)師,溫州醫(yī)科大學(xué)臨床檢驗診斷學(xué)碩士。2018 年在省人民醫(yī)院進(jìn)修流式細(xì)胞和骨髓形態(tài),現(xiàn)主要從事流式血液病診斷工作。主持:金華市課題 1 項,參與省自然 3 項,國自然 3 項,以第一作者和通訊作者發(fā)表 SCI 文章 3 篇,參編《尿液有形成分圖譜新解及病例分析》一書。
下期預(yù)告
患兒女,10 歲,主訴高熱伴腹痛 4 天入院。入院查體:急性病容,體溫 38.5℃,呼吸急促,雙側(cè)頸部、腋窩、腹股溝可觸及腫大淋巴結(jié),最大 1.0×1.5 cm,質(zhì)軟,有壓痛感,活動度可;脾大,肋下約 2 cm,質(zhì)軟無壓痛,余無明顯陽性體征。血常規(guī)示:Hb135 g/L,WBC19.6×109/L,LYM:78%,PLT142×109/L。
- 涂片結(jié)果顯示骨髓增生活躍,原始細(xì)胞比例不好,粒細(xì)胞比例減低,淋巴細(xì)胞比例升高。
- 流式結(jié)果未見明顯異常原始細(xì)胞,粒細(xì)胞相對比例減低,淋巴細(xì)胞相對比例升高……
最終的診斷結(jié)果可能是什么?點擊閱讀原文給出你的猜測,下期內(nèi)容更新后我們會在評論中抽取正確或相近的答案送出精美禮品來鼓勵大家的積極參與。
責(zé)編:杭璐
題圖來源:站酷海洛
點擊閱讀原文參與活動
閱讀原文
最新動態(tài)
更多